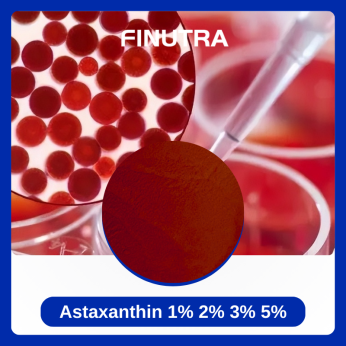

Finutra Inc.
SILVER SPONSORS
Information
Finutra Biotech was established in 2005 as a marketing brand of Jianhe Biotech. we offer a broad array of raw materials and functional ingredients as a manufacturer, distributor and supplier for global Beverage, Nutraceutical, Food, Feed and Cosmeceutical industry.
Quality, implementation and traceability are the foundations of our structure and goals. Our processes are clearly definedand meet top industry standards.
Contract Manufacturers/Service Providers
BlendingBottling, Capsules/TabletsBottling, LiquidsEncapsulating, VegetarianGranulatingLiquid ExtractsMicro-Encapsulation PastesPowder BlendsSports NutritionSpray DryingSprays, LiposomeTableting
Independent Service Providers
Supply Chain Management: SourcingSupply Chain Management: Warehousing
Ingredient Supplier: Herbs/Botanicals
AcaiAlfalfaBacopaCranberry ExtractCranberry Seed ExtractHerb Extracts, DryHerb Extracts, LiquidHerb Extracts, StandardizedPine Bark ExtractPumpkin Seed Extract
Ingredient Supplier: Minerals
MagnesiumManganeseMinerals, ChelatedMinerals, MicroencapsulatedZinc
Ingredient Supplier: Related Components
Capsules, SoftgelsCoatingsFood Grade
Ingredient Supplier: Specialty
5-HTPAcetyl-L-CarnitineAlpha Lipoic AcidAmino AcidsAntioxidantsBerberineCarotenoidsCarotenoids: AstaxanthinCarotenoids: Beta-CaroteneCarotenoids: LuteinCarotenoids: LycopeneCarotenoids: ZeaxanthinCoQ10 (Coenzyme Q10)CurcuminFlavonoidsFlavonoids: DiosminFlavonoids: LuteolinFlavonoids: QuercetinMelatoninSAM-eUbiquinolUbiquinone
Ingredient Supplier: Vitamins
Vitamin AVitamin BVitamin CVitamin DVitamin EVitamin K2Vitamins, MicroencapsulatedVitamins, NaturalVitamins, PremixVitamins, Synthetic
Regions
China